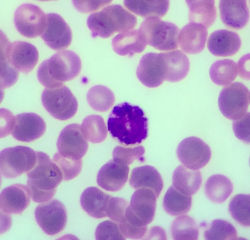
NUEVAS 4 JULIO 2043

top of page

UAEMex- UAP-Chimalhuacán
COORDINACIÓN DE MÉDICO CIRUJANO
Atlas Virtual de Histología
Créditos.
Material elaborado por los profesores:
Joab Josue Díaz Martínez, Lizbeth Ramos Reyes, José Manuel Castrejón Ramírez, Alvaro Jiménez Galindo y
Miguel Alejandro Lecuona Rodríguez
1. Microscopia
2. Técnica Histológica
![]() |
|---|
![]() |
![]() |
![]() |
![]() |
![]() |
![]() |
![]() |
![]() |
![]() |
![]() |
![]() |
![]() |
![]() |
|---|
![]() |
![]() |
![]() |
![]() |
![]() |
![]() |
![]() |
![]() |
![]() |
![]() |
![]() |
![]() |
![]() |
![]() |
![]() |
![]() |
![]() |
![]() |
![]() |
![]() |
![]() |
![]() |
![]() |
![]() |
|---|
![]() |
![]() |
![]() |
![]() |
![]() |
![]() |
![]() |
![]() |
|---|
![]() |
![]() |
![]() |
![]() |
![]() |
![]() |
![]() |
![]() |
![]() |
![]() |
![]() |
3. Biología Celular
4. Tejido Epitelial
5. Tejido Conjuntivo
![]() |
|---|
![]() |
![]() |
![]() |
![]() |
![]() |
![]() |
![]() |
![]() |
![]() |
6. Tejido Cartilaginoso
![]() |
|---|
![]() |
![]() |
![]() |
7. Tejido Óseo
![]() |
|---|
![]() |
![]() |
9. Tejido y Sistema Nervioso
![]() |
|---|
![]() |
![]() |
![]() |
![]() |
![]() |
![]() |
![]() |
![]() |
![]() |
![]() |
![]() |
![]() |
![]() |
8. Tejido Muscular
![]() |
|---|
![]() |
![]() |
![]() |
![]() |
![]() |
![]() |
![]() |
10. Ojo
![]() |
|---|
![]() |
![]() |
![]() |
![]() |
![]() |
![]() |
![]() |
![]() |
![]() |
![]() |
![]() |
![]() |
11. Sangre y Médula Ósea
![]() |
|---|
![]() |
![]() |
![]() |
![]() |
![]() |
![]() |
![]() |
![]() |
![]() |
![]() |
![]() |
![]() |
![]() |
12. Tejido y Órganos Linfoides
![]() |
|---|
![]() |
![]() |
![]() |
![]() |
![]() |
![]() |
![]() |
![]() |
![]() |
![]() |
![]() |
![]() |
13. Glándulas Digestivas
![]() |
|---|
![]() |
![]() |
![]() |
![]() |
![]() |
![]() |
![]() |
![]() |
![]() |
![]() |
![]() |
bottom of page